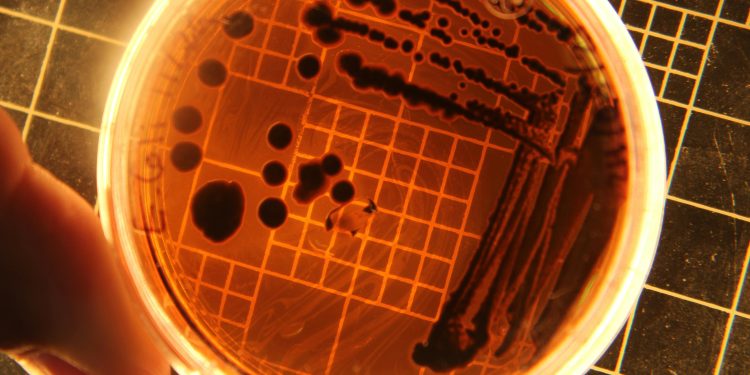

Negli ultimi mesi, l'Europa e i paesi dei Balcani si sono trovati di fronte a un preoccupante focolaio di Salmonella collegato al consumo di semi germogliati. L'European Centre for Disease Prevention and Control (Ecdc) e l'European Food Safety Authority (Efsa) hanno emesso un allarme per mettere in guardia la popolazione e le autorità sanitarie sull'importanza di adottare misure preventive per contenere la diffusione dell'infezione.
La Salmonella è un batterio che può causare gravi infezioni intestinali, con sintomi che vanno da febbre, diarrea e crampi addominali a nausea e vomito. Nei casi più gravi, l'infezione da Salmonella può portare a complicazioni come la setticemia e l'artrite. È particolarmente pericolosa per i bambini, gli anziani e le persone con un sistema immunitario compromesso.
Secondo le autorità sanitarie, il focolaio di Salmonella è stato ricondotto al consumo di semi germogliati contaminati. I semi germogliati sono considerati un alimento a rischio di contaminazione batterica poiché i semi stessi possono essere contaminati durante la produzione o la coltivazione e i germogli possono fornire un ambiente ideale per la proliferazione dei batteri.
L'Ecdc e l'Efsa hanno quindi raccomandato alle autorità sanitarie di intensificare i controlli sulla catena di produzione e distribuzione dei semi germogliati, nonché di informare i consumatori sui rischi associati al consumo di questi alimenti. Inoltre, è importante che i consumatori seguano correttamente le pratiche di igiene alimentare, come lavare accuratamente frutta e verdura prima del consumo e evitare il consumo di alimenti crudi o poco cotti.
Le autorità sanitarie stanno lavorando per individuare la fonte precisa del focolaio di Salmonella al fine di adottare misure mirate per prevenire ulteriori casi di infezione. Nel frattempo, è fondamentale che i consumatori prestino attenzione all'origine dei prodotti che acquistano e che seguano le indicazioni delle autorità sanitarie per ridurre il rischio di contaminazione.
La diffusione della Salmonella attraverso i semi germogliati è un promemoria dell'importanza della sicurezza alimentare e della necessità di adottare pratiche corrette nella gestione e preparazione degli alimenti. Solo attraverso la collaborazione tra autorità sanitarie, produttori, distributori e consumatori sarà possibile proteggere la salute pubblica e prevenire focolai di infezioni alimentari come quello attuale.